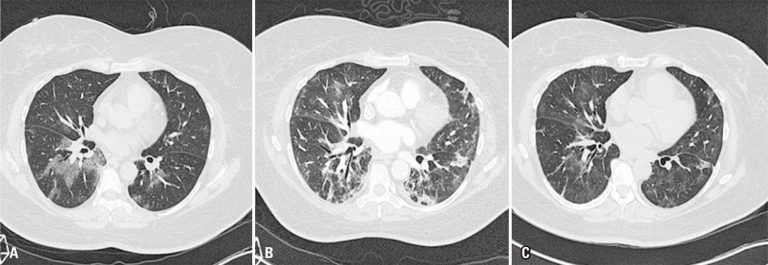

einstein (São Paulo). 02/out/2020;18:eCE5974.
Evolução temporal dos achados tomográficos da infecção pulmonar na COVID-19
DOI: 10.31744/einstein_journal/2020CE5974
Caro Editor,
Com muito entusiasmo, lemos o excelente artigo de revisão intitulado “Achados da COVID-19 identificados na tomografia computadorizada de tórax”, de autoria de Rosa et al.,() publicado no último número desta revista. O referido trabalho ilustra com casos didaticamente apresentados a importância da tomografia computadorizada (TC) de tórax na detecção das manifestações pulmonares da doença pelo coronavírus 2019 (COVID-19), sem discutir seu papel no seguimento evolutivo da doença. Embora saibamos não ter sido este um escopo dos autores, gostaríamos de complementar essa discussão com alguns pontos referentes ao impacto desse método no prognóstico e na evolução (sobretudo a longo prazo) da COVID-19.
[…]
8.459